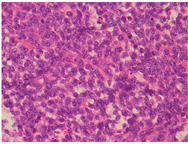

探讨小肠转移性上皮样血管肉瘤(EA)的临床表现、组织学特征、诊断及鉴别诊断,进一步提高对该病的认识。
回顾性分析我院收治的2例小肠转移性EA的临床资料,进行光镜及免疫表型观察,并复习相关文献报道的3例小肠转移性EA。
小肠转移性EA发病年龄36~80岁(平均62岁),男3例,女2例。临床出现腹痛2例、黑便2例、贫血及钡灌肠异常1例。原发病灶2例来源于大腿软组织,2例来源于脏器-肝和肺,1例原发灶不详。病理组织学改变与原发性EA病灶相似,均表现为巢片状或索状排列的上皮样细胞,异型性明显,可见核分裂像、核仁、血窦及血管网结构。免疫表型4例表达CD31,3例表达Fli-1、ERG,2例表达ⅧRAG、CKpan。
小肠转移性EA临床少见,预后较差,临床主要表现为腹痛、黑便及贫血等消化道症状,各部位EA均可转移,临床诊断较困难,但病理组织学改变有特点,结合临床病史及免疫组化染色血管内皮相关抗原呈阳性有助于诊断。
版权归中华医学会所有。
未经授权,不得转载、摘编本刊文章,不得使用本刊的版式设计。
除非特别声明,本刊刊出的所有文章不代表中华医学会和本刊编委会的观点。
上皮样血管肉瘤(epithelioid angiosarcoma, EA)是肿瘤细胞呈上皮样的血管肉瘤,是血管肉瘤的一种特殊类型,多发生于深部软组织内,占所有血管肉瘤的20%~30%[1]。EA极少发生于脏器,易复发和转移,其转移部位最常见于颈部淋巴结,其次见于见于肺、肝、脾脏和骨等处[2,3]。转移至小肠临床上罕见,现报道我院先后收治的2例小肠转移性EA,并结合文献复习对其临床表现、病理学特征、免疫表型及鉴别诊断进行探讨,进一步提高对该病的认识。
烟台市烟台山医院2016年2月和2020年5月诊断的2例小肠转移性EA,原发灶分别位于左大腿外侧及左腹股沟软组织和右肺上叶,转移肿瘤分别位于距屈氏韧带60cm处和屈氏韧带远端小肠。2例患者临床资料包括临床表现、性别、年龄、肿瘤部位、大小、影像学表现及既往手术病史。
患者男,36岁。10d前无明显诱因出现腹痛,为右侧腹持续性胀痛,阵发性加重,程度中等,无他处放射;伴有恶心、呕吐,为非喷射性呕吐,呕吐物为含胆汁胃液,无咖啡色液体;肛门排气减少,无排便,无腹泻黑便,无黏液及脓血,无里急后重。无畏寒、发热、皮下出血。10d来逐渐出现消瘦、心慌、口渴、心悸、头晕。曾于当地医院就诊,行腹部CT示"横结肠肠壁增厚狭窄,考虑肿瘤",临床诊断为"横结肠肿瘤并梗阻",并以"肠梗阻"给予治疗。效果不佳,为求进一步治疗于2016年2月11日来我院,收入院治疗。患者自发病以来精神状态较差,睡眠一般,小便正常,体力情况较差。实验室检查白细胞计数9.59×109/ml,红细胞计数3.46×1012/ml,血红蛋白108g/L;免疫学检查肿瘤生长因子70.00U/ml;大便常规+潜血(-)。完善相关检查后行部分小肠切除术,术中见腹腔内少量腹水,肝、胆、胃、脾、盆腔、结肠及系膜均未见明显异常。距屈氏韧带60cm处小肠见一约15cm×8cm大小肿物,侵透浆膜,近端肠管显著扩张,余小肠及系膜未及明显异常。决定行部分小肠切除术。既往2014年4月15日曾行软组织彩超发现"左大腿外侧及左侧腹股沟肿物",于4月22日行肿瘤切除术。术中见肿瘤位于腹股沟外环口外侧,皮下层及腹外斜肌腱膜之间,大小5cm×4cm×3cm,将肿物完整切除。术后病理诊断为左大腿及左腹股沟EA。术后行4个周期化疗。2015年4月1日因左腹股沟肿瘤复发入院,4月9日手术切除,术后病理组织像同前,诊断EA复发。
例2患者男,55岁。患者半月前在当地医院行PET-CT发现"左侧腹腔多段肠壁增厚,考虑恶性病"。患者无腹痛、腹胀,无恶心、呕吐,无心慌、气促,偶有黑便,无脓血便,无里急后重,无排便习惯改变。为行进一步诊治,于2020年5月9日来院就诊,门诊收住入院。实验室检查白细胞计数22.16×109/ml,红细胞计数2.67×1012/ml,血红蛋白59g/L,血小板计数599.00×109/L;大便常规+潜血(-)。腹部CT示左侧中上腹部分小肠管壁明显增厚,局部形成软组织影,增强扫描明显强化,周围见多发淋巴结肿大影及团块状软组织密度影;右肾囊肿,盆腔少量积液。5月12日行腹腔镜下腹腔探查术+小肠部分切除术,探查未见肝、胆、脾及结肠肿瘤,肿瘤位于屈氏韧带远端,大小约10cm×6cm;其肠系膜淋巴结肿大,行小肠部分切除术。既往2019年8月3日患者查体时发现左肺上叶占位入院治疗,8月8日行左肺上叶切除术+淋巴结清扫术。术后病理报告为(左肺上叶)恶性肿瘤,结合免疫组化染色结果符合上皮样血管肉瘤,伴大片坏死,肿瘤大小3.0cm×2.5cm×2.0cm并紧邻肺被膜;未累及支气管,支气管切缘未见肿瘤,其余肺组织呈充血及出血改变,支气管旁触及淋巴结未见肿瘤(0/1)。
所有手术切除标本均经10%中性甲醛液固定,常规脱水,石蜡包埋,4μm厚切片,HE染色,光镜观察。免疫组化染色均采用EnVision法,抗体CKpan、Vimentin、CD3l、CD34、ERG、Fli-1、SMA、S-100、SOX-10、CD117、CD99、Dog-1、CD3、CD20和Ki-67均购自北京中杉金桥生物技术有限公司。采用美国罗氏公司生产的BenchMark ULTRA全自动免疫组化仪,操作均严格按照以下步骤进行:(1)脱蜡和水化;(2)抗原修复;(3)阻断内源性过氧化物酶;(4)滴加抗体或空白对照试剂;(5)滴加酶标聚合物;(6)滴加显色剂;(7)复染;(8)脱水、透明、封片;(9)结果判读。
例1患者小肠一段,长42cm,一侧切缘周径4.5cm,另一侧切缘周径9.0cm。距4.5cm切缘23.0cm,距9.0cm切缘14.0cm处见一肿物,肿物大小11.0cm×6.0cm×2.5cm。肿物中央部缺损,呈穿透性空腔状,穿透肠管,侵及肠系膜,周边实性,切面灰粉灰黄色,质软脆,烂鱼肉状。其余肠黏膜皱襞尚好,未见著变。查见肠系膜淋巴结10个,最大者最大径1.3cm,最小者最大径0.5cm。另见肿物2个,大小分别13cm×6cm×4cm和14.0cm×7.5cm×4.0cm。表面尚光滑无包膜,切面灰白灰褐暗红色,质软脆,烂鱼肉状。
例2患者小肠肠管一段(图1),长33cm,一侧切缘周径5.0cm,另一侧切缘周径6.2cm。距5.0cm切缘13.0cm,距6.2cm切缘17.5cm处小肠黏膜见一浸润溃疡型肿物,肿物大小9cm×5cm×2cm。另距5cm切缘26cm,距6.2cm切缘2.5cm处小肠黏膜见一隆起型肿物,肿物大小9cm×6cm×3cm。肿物切面均灰白色,质软、脆,肉眼似侵至浆膜层。其余小肠黏膜皱襞尚好,未见著变。肠系膜淋巴结7个,最大径0.5~4.9cm。


例1患者肿瘤细胞排列呈片状、索条样及网状,或形成交通状的血窦网,位于肠壁全层。瘤细胞呈上皮样,大小比较一致;核呈圆形、卵圆形或梭形,细胞核大、淡染;部分细胞核可见小核仁,异型性明显,核分裂像易见(图2,图3图4);间质伴灶片状出血。与2年前左大腿外侧及左侧腹股沟EA肿瘤组织学相似(图5)。








例2患者上皮样肿瘤细胞呈实性片状排列,位于黏膜下、肌层及浆膜层。瘤细胞呈圆形及卵圆形,核大淡然,异型性更明显;可见大红核仁,局部可见血窦及血管网结构;间质可见慢性炎细胞浸润(图6,图7图8)。与1年前左肺上叶EA肿瘤组织学结构类似(图9)。








2例肿瘤细胞均表达Vimentin、CD31、Fli-1、ERG(图10,图11);部分表达D2-40;不表达CD34、CD99、SMA、S-100、SOX-10、CD117、Dog-1、CD3、CD20,例1 Ki67阳性细胞指数约95%,不表达CKpan;例2 Ki67阳性细胞指数约70%,表达CKpan(图12)。






例1患者小肠间叶源性恶性肿瘤,结合病史及免疫组织化学染色结果符合转移性EA。肿瘤大小11.0cm×6.0cm×2.5cm,肠壁全层至浆膜外均见肿瘤组织,手术标本两切缘未见肿瘤。其余肠黏膜呈慢性炎改变,肠系膜淋巴结未见明确转移瘤(0/10)。例2患者小肠恶性肿瘤,结合临床病史及免疫组化结果符合转移性EA。肿瘤两处组织学改变相同,大小分别为9cm×5cm×2cm、9cm×6cm×3cm。肿瘤侵至浆膜层,肠系膜淋巴结可见转移性肿瘤(3/7),手术标本两侧切缘未见肿瘤。其余小肠黏膜呈慢性炎改变。
例1患者小肠肿瘤切除术后半年因肝内多发转移、双下腹壁多发转移、盆腹腔转移伴胸腹盆腔大量积液、双肺多发转移死亡。例2患者小肠肿瘤切除术后2个月,于2020年7月23日行恶性肿瘤化疗,一般情况可,已出院服药治疗。
EA是20世纪80年代以来逐渐被认识的一种肿瘤,最早于1982由Enzinger和Weiss首先描述[4]。肿瘤细胞呈上皮样,圆形、卵圆形或梭形,胞质丰富淡染嗜酸,细胞核较大呈圆形或卵圆形,有的可见多核、巨核细胞,可见明显核仁及病理性核分裂像。大多数瘤组织内可见互相吻合的血管腔样结构,内衬具有非典型性的血管内皮细胞。多见于软组织肿瘤,小肠原发及转移性EA临床上罕见。检索近40年国内外参考文献,国外2例,国内1例,加上本文2例共5例。主要临床病理特征详见表1[5,6,7]。小肠转移性EA发病年龄36~80岁,平均年龄62岁,其中男3例,女2例,提示好发于老年男性。临床主要表现为腹痛、黑便等消化道症状,个别病例出现贫血症状。原发病灶2例来源于大腿软组织,2例来源于脏器-肝和肺,1例原发灶不详,提示各部位EA都可转移至小肠。病理组织学改变与原发性EA病灶相似,均表现为巢片状或索状排列的上皮样细胞,异型性明显,可见核分裂像及核仁,可找见血窦及血管网结构。免疫表型4例表达CD31,3例表达Fli-1、ERG,2例表达ⅧRAG、CKpan。CD31跨膜糖蛋白在内皮细胞中强表达,敏感性和特异性优于CD34、Ⅷ因子相关抗原。CD34大多数血管源性肿瘤阳性,部分血管肿瘤以外的软组织肿瘤亦阳性,特异性较低。FLI-1特异性及敏感性都优于CD31和CD34,其阳性部位为核,易于观察。ERG为原癌基因,所有良恶性血管肿瘤均表达[8],优于CD31和CD34,着色部位为靶细胞核,是最敏感和特异性标志物。ⅧRAG仅由内皮细胞构成,通常存在于Weibel-Palade小体和巨核细胞中,高级别血管肉瘤中因Weibel-Palade小体稀少,阳性率不足10%~15%。因此对于小肠分化差的上皮样细胞血管肉瘤,免疫组化染色只有联合应用多个血管源性标志物,才能更好的明确诊断。

文献报道的小肠转移性上皮样血管肉瘤5例临床病理特征
文献报道的小肠转移性上皮样血管肉瘤5例临床病理特征
| 序号 | 研究者 | [文献] | 性别 | 年龄 | 临床主诉 | 原发部位 | 转移部位 | 免疫表型阳性表达 | 治疗 | 预后 |
|---|---|---|---|---|---|---|---|---|---|---|
| 1 | Ord6fiez等 | [5] | 女 | 80 | 贫血和钡灌肠异常 | 不详 | 空肠 | FⅧRAG、Vimentin | 手术切除 | 术后8d呼吸衰竭死亡 |
| 2 | Tseng等 | [6] | 女 | 64 | 黑便 | 肝脏 | 十二指肠 | CD31、CD34、FⅧRAG | 手术切除 | 术后9d死于感染性休克 |
| 3 | 袁明明等 | [7] | 男 | 74 | 反复黑便 | 右大腿 | 幽门下150cm小肠 | CD31、ERG、Fli-l、CKpan | 手术切除 | 术后5个月一般情况好 |
| 4 | 董成功等 | 本组例1 | 男 | 36 | 持续性腹痛 | 左大腿外侧及腹股沟 | 距屈氏韧60cm小肠 | Vimnetin、CD31、Fli-1、ERG | 手术切除 | 术后半年全身广泛转移死亡 |
| 5 | 董成功等 | 本组例2 | 男 | 55 | 偶有腹痛 | 左肺上叶 | 屈氏韧远端小肠 | CKpan、Vimentin、CD31、Fli-1、ERG | 手术切除 | 治疗观察中 |
由于EA分化较差,确定组织学类型及来源有一定难度,须要借助临床病史、免疫组化染色结果及镜下组织学改变。2例患者小肠发病前均有明确的EA病史,小肠转移灶肿瘤细胞与原发灶相比异型性更明显,核分裂像更多,肿瘤细胞增殖指数更高,提示肿瘤预后更差。
小肠转移性EA由于肿瘤细胞分化较差,主要与以下小肠肿瘤鉴别。①低分化腺癌:它是小肠最常见肿瘤,肿瘤细胞一般排列呈实性、巢片状或腺样,异型性明显,核分裂象易见;免疫组化染色一般CKpan、EMA呈阳性,而Vimentin和血管内皮标记物CD31、CD34、ERG、Fli-1阴性。②上皮样胃肠间质瘤:肿瘤细胞可呈巢状或片状分布,或呈透亮、空泡状,核呈圆形或卵圆形,显示明显的多形性;免疫组化DOG1、CD117、CD34阳性,而血管内皮标记物阴性,易于鉴别。③弥漫性大B细胞淋巴瘤:它是小肠中最常见的淋巴瘤,肿瘤细胞较大,异型性明显,弥漫分布,或排列呈片块状,胞核呈空泡状,核仁明显;免疫组化染色CD20、CD79α等B细胞淋巴瘤标记物弥漫阳性,而血管内皮标记物阴性。④无色素性恶性黑色素瘤:肿瘤细胞有明显异型性,瘤细胞呈圆形、卵圆形或短梭型,核大、淡染呈上皮样,核仁明显,易与EA混淆;免疫组化瘤细胞S-100、HMB-45、Melan-A呈阳性,但血管内皮标记物阴性。⑤上皮样肉瘤:一种瘤细胞分化方向尚不明确的恶性肿瘤,分为经典型和近端型。经典型的上皮样肉瘤多发生于手指、手掌、腕部、前臂伸侧面和肘面以及下肢等软组织,发生于小肠少见;近端型上皮样肉瘤多发生于盆腔、会阴肛旁区、腹股沟、耻骨区、外生殖区等部位,临床表现为软组织深部肿块,很少发生于小肠。镜下瘤细胞呈上皮样,结节中可见明显出血、囊性变及扩张的血管样结构,极易误诊为EA,瘤细胞表达CKpan、CK19、EMA,部分表达CD34。新近文献报道显示上皮样肉瘤可弱表达ERG和Fli1,一般不表达CD31。与其他上皮性肿瘤不同的是,上皮样肉瘤不表达E-cadherin,也不表达INI1,但可表达V-caddherin有助于与EA鉴别。⑥假肌源性血管内皮瘤/上皮样肉瘤样血管内皮瘤:多发生于浅表软组织(皮肤和皮下),也可发生于深部肌肉组织内,并可累及骨表面,但少见于小肠。镜下肿瘤细胞由胖梭形或上皮样细胞构成,瘤细胞常呈周界不清的结节状、疏松的条束状或片状排列;瘤细胞胞质丰富,胞核呈空泡状,可见较为明显的核仁;无或偶见水泡细胞,间质内常可见散在中性粒细胞,可伴有炎症性或液化性坏死(EA常有血管形成,并可见内衬多层细胞,间质不见中性粒细胞);免疫组化虽然也表达CKpan, CD31、Fli1、ERG,但不表达CD34,特异性表达FOSB,必要时分子病理检测对鉴别诊断有辅助作用[9]。⑦卡波西肉瘤:主要与累及胃肠道的卡波西肉瘤AIDS相关型鉴别,镜下以弯曲条束状增生的梭形细胞和内含红细胞的裂隙样血管为特征;典型的卡波西肉瘤无明显异型性,核分裂象少见,少数病例肿瘤细胞分化较差,异型性明显,核分裂象增多;免疫组化染色HHV-8、LNA-1阳性,结合临床病史有助于鉴别。⑧恶性间皮瘤:主要与上皮样间皮瘤鉴别,上皮样间皮瘤的一个基本特点就是瘤细胞无明显异型性,瘤细胞形态比较一致,呈立方状、扁平状,胞质丰富,或呈空泡状;大多数肿瘤细胞可见明显核仁,但也有部分病例核仁不明显;免疫组化染色calretinin、CK5/6、WT1、D2-40等阳性间皮瘤标记物阳性,以calretinin特异性最高,而血管内皮标记物阴性有助于鉴别。
小肠转移性EA治疗手段主要以手术切除为主,术后局部放疗可以提高肿瘤的局部控制率并延长生存时间[10,11],但肿瘤临床过程极具侵袭性,治疗效果不理想[12],约80%病例发生转移[13],预后差[14]。大部分患者术后或在诊断后因肠道出血无法控制或急性呼吸衰竭原因几个月后死亡,平均生存期30周左右,>1年生存的极为罕见[15]。文献报道的5例患者中1例术后8d因呼吸衰竭死亡;1例术后9d因感染性休克死亡;1例术后半年因全身广泛转移死亡。2例术后不足1年,仍在治疗随访中。
本人及其他作者宣称没有任何利益冲突,未接受任何不当的职务或财务利益。